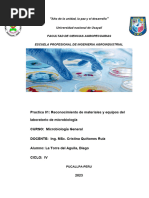
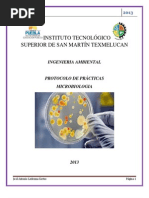

0% encontró este documento útil (0 votos)
69 vistas7 páginasTécnicas de Pipeteo en Microbiología
El documento describe los procedimientos y equipos necesarios para trabajar de forma segura en un laboratorio de microbiología. Explica que se debe mantener un ambiente limpio y estéril para evitar la contaminación de muestras. También enumera los equipos clave como la estufa de incubación, refrigerador, autoclave y jarra de anaerobiosis, así como los procedimientos para el uso correcto de pipetas.
Cargado por
Tabata SantanaDerechos de autor
© © All Rights Reserved
Nos tomamos en serio los derechos de los contenidos. Si sospechas que se trata de tu contenido, reclámalo aquí.
Formatos disponibles
Descarga como DOCX, PDF, TXT o lee en línea desde Scribd
0% encontró este documento útil (0 votos)
69 vistas7 páginasTécnicas de Pipeteo en Microbiología
El documento describe los procedimientos y equipos necesarios para trabajar de forma segura en un laboratorio de microbiología. Explica que se debe mantener un ambiente limpio y estéril para evitar la contaminación de muestras. También enumera los equipos clave como la estufa de incubación, refrigerador, autoclave y jarra de anaerobiosis, así como los procedimientos para el uso correcto de pipetas.
Cargado por
Tabata SantanaDerechos de autor
© © All Rights Reserved
Nos tomamos en serio los derechos de los contenidos. Si sospechas que se trata de tu contenido, reclámalo aquí.
Formatos disponibles
Descarga como DOCX, PDF, TXT o lee en línea desde Scribd